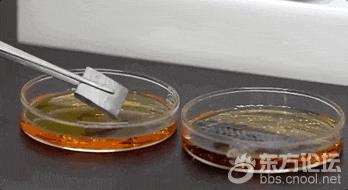

作为航天、航空等领域的优选材料,碳纤维可谓“刚柔并济”,它兼备纤维的“柔”,虽细如发丝,却比钢还硬;此外,碳纤维耐高温、耐腐蚀能力强,因此被称为“黑色黄金”“新材料之王”“地表超强材料”。
这次首发的T1200级超高强度碳纤维,由中国建材集团自主研发,值得关注的是,它并非实验室里的样品,而是已经具备百吨级量产能力的工业化产品。这也让我国成为全球首个实现该级别碳纤维百吨级量产的国家。
据了解,T1200级碳纤维的直径还不到我们头发丝的十分之一,但其拉伸强度却是普通钢材的10倍,密度却只有钢材的四分之一,轻且坚韧的特点十分突出。凭借这些优异性能,它可以广泛应用于航空航天、低空经济、人形机器人等战略性新兴产业领域。
【相关阅读】
碳纤维在生产过程中经历了近2000℃高温的碳化,化学性能非常稳定。将金属片和碳纤维织片放进主要成分是盐酸和硝酸的王水中,金属片瞬间发生剧烈反应,而碳纤维织片泡了一会儿后都没有任何变化。用喷枪进行火烧测试,碳纤维编织的布料中间已经被烧红,却没有冒烟,更不会被点燃,安全性能非常好。通过电子显微镜放大800倍,对比头发丝和T1200级碳纤维,头发丝表面布满鳞片,直径约67微米,而T1200级碳纤维丝直径还不到4.5微米。△放大800倍的头发丝(左)与T1200级碳纤维(右)。一根由12万根碳纤维丝拧合而成的碳纤维绳,绷紧以后的理论直径还不到2毫米,就可以拉动满载着54个成年人的大货车。T1200级超高强度碳纤维整个生产流程跨越1000多米高温生产线,需要3000多个精密工艺实时精准控制。碳纤维的生产线看起来像一个纺织车间,一排排白色的柱体就是碳纤维的原丝。预氧化在内部温度200℃到300℃之间的氧化炉中进行,最考验火候的把控。就像煎3分熟的牛排,先用温火慢煎,里面既不能太生,表面也不能太焦。它的作用是让原丝更耐热,在后面的高温碳化过程中不会熔断。在十几层的S型往返卷轴上,最先进入氧化炉的原丝从白色开始变得金黄,随着进出氧化炉的次数越来越多,原丝由下往上,颜色变得越来越深。从金黄到深黄,再到棕色,最后变成黑色。接下来就到了无氧碳化环节。低温炉里的温度是600~1000℃,原丝里的非碳物质在这里被基本去除;高温炉里的温度达1000~2000℃,在这里,材料真正完成碳化,成为碳纤维。